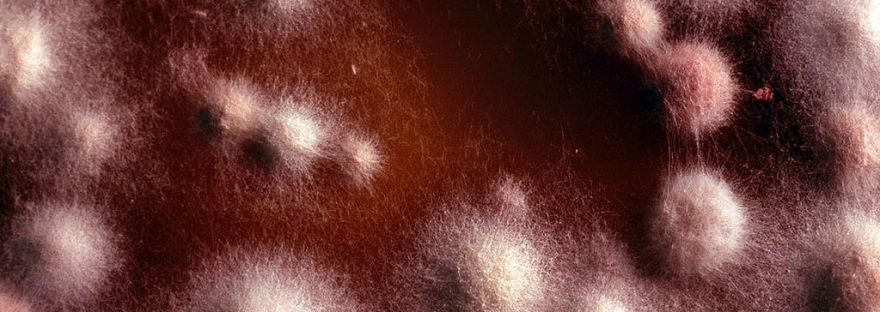

I had a spare ten minutes at work and I thought that I’d give this post a go to see what I could come up with. It was such a productive ten minutes, I would have been as well working. Nothing! Zilch! Bugger All!!
For me, my job spoils everything. I like to eat but I won’t eat at work because I enjoy eating and I can’t enjoy anything whilst I’m there. I also love to read a paper. I know that this is a dying art. But you do still see some dinosaurs going into the newsagents of a morning, buying a paper and tucking it under their arm. I’m not sure if anyone under thirty even knows what a paper is. If it’s not their phone, it’s nothing!
Anyway, back to my job, I work and only drink water. Most of us males from this part of the world only use water to wash in, so this is a self-upsetting experience to enhance the shite that is employment.
I’m now at the stage where there is a whisper that I need to do a qualification. This is pissing me off some-what.
I love writing, but I hate being bored. So any forced upon me repetitive content, never being able to fail certificate, will only bore me and I will want to hurt people.
Certificates and qualifications are like the shiny / shiny to deranged Magpies. Some folks must have them. They introduce themselves as them:
‘Well hello there. I’m Calum and I have a diploma. I’m an academic’
Fuck you Calum. Pour some petrol over your head, set the said diploma on fire and LET IT FUCKING GO!
I associate writing with fun, challenge and relaxation. It has nothing to do with despair, boredom and wanting to pull my toe-nails off. Passing the damn thing isn’t the problem, not wanting to, is!
I think this is the same mind-set we all have when reading a book. Because this is a pastime that we normally enjoy, we have no tolerance for something that bores. We don’t give it long before we decide that it is a bit pants and we hand it onto that relative that we don’t like. (Or we could use it to set Calum on fire again.)
I actually hate myself for not finishing a book, especially one that I have chosen to read. But this has happened on the odd occasion with the universal condemnation of ‘Life’s too short!!’.
It would be great to live to that ideal completely and not put up with anything that annoys us. How refreshing would it be to try just once, and say in a loud and happy voice…
‘Nope!! Not on your Nellie!!’
It would be even better if we didn’t need to try in the first place, as in…
‘THAT’LL BE SHINING BRIGHT!!’
I blame mortgages and thinking of someone more than yourself that causes us to do all the pish that makes us unhappy. You can’t let your partner or kids go hungry, so you need to suck it up.
I sometimes think if my wife found someone better and I was on my own, I’d be in a wee hut in the woods somewhere. I’d lick the wildlife for sustenance. (I couldn’t kill the beasties, so woodland lollipops would have to do. I would need something to ferment and I don’t mean the fungus that would be growing between my toes. (That was a horrible image, but that was the best out of the two I’d thought of!)
And as long as I had a few books along for company, I’d be a happy but minging man. When I think on it, Gwen wouldn’t need to look very far to do better!
Books and stories keep us sane. Life and work make us dream!!
OK, onto this week’s stories. Three new authors for your entertainment.
Topics include depression, marital abuse, a fair, a life emphasised and two laid-back guys. As always our initial comments follow.
Our first author of the week was our first new author of the week!
We welcome Donna Aversa and hope she is having fun with the site.
On Monday we were very happy to publish Donna’s short story ‘Annie’s Shoes.’
‘Sparse, clever and harrowing.’
‘I found this really sad.’
‘Very well done with a great pace, perfect for Flash Fiction’.
Another new writer was up on Tuesday. We also extend the same welcome to Brenda Catron. ‘Two Too Many‘ was Brenda’s first story on the site.
‘This nearly brought me to tears.’
‘You felt as if you were going along with the poor soul’s breakdown.’
‘Brenda has captured this woman’s desperation and hopelessness so very accurately’.
We had a returning author on Wednesday. David Turko has added to his criminally light back catalogue with ‘Dude’s Chilling.’ Hopefully we will get more from him very soon!!
‘I was envious of them being in that place at that time of their lives.’
‘For whatever reason, this had charm and nothing really mattered.’
‘It was fun to chill with them.’
Our third new author was next up. Oh as well as the welcome we have extended to all our new writers, we would also ask for more stories from all of them!!
‘The Deep End‘ from Sarah Dara was published on Thursday.
‘Great tone and atmosphere.’
‘We were taken along, following her thoughts.’
‘The sex references were very cleverly done.’
And we finished on Friday with Martin Clayton who added to his 4th story, with his 5th.
‘The Louder You Scream‘ was an excellent way to finish off the week.
‘The description of The Fair was excellent with the pathos of the ageing loner.’
‘Very visual. A nicely drawn main character.’
‘A vivid piece of writing.’
OK folks, that’s us for another week!
I may not be able to do this much longer as my preparation for my work based studies will be gouging my eyes out and cutting off my hands. Shit! There’s a problem! Which do you do first??
Hugh
Banner Image – Athlete’s Foot Fungus – Well Hugh you mentioned it!! By Ecorahul (Own work) [CC BY-SA 3.0 (http://creativecommons.org/licenses/by-sa/3.0) or GFDL (http://www.gnu.org/copyleft/fdl.html)%5D, via Wikimedia Commons

Diane,
Your images always make me smile. This one made me itch or heave or itch and heave!! Excellent!!
Thanks as always!!
Hugh
LikeLike
I couldn’t resist – sorry about the itch!!!
LikeLike
Could have been worse, depending on where the itch was!!
Thanks again Diane!
Hugh
LikeLike
Ah, love, let us be true. In this world so glittering there is no certitude, nor peace, nor help for pain. But there are firebugs, fuzzy suckers, and guys who ain’t as fun as they used to be. One might say that they suck and roar; after the darkling God broke the mould
LikeLike
I reckon ‘Fuzzy Sucker’ would be a cracking name for a cat.
Thanks as always, your comments are a treat to read and a smile to instigate!!
Hugh
LikeLiked by 1 person
That was brutal. Worse than my worst reviews, and that is saying something. It made me want to hear your opinion about politicians, rappers, pop stars and “reality” people.
LikeLike
Thanks Doug!!
Yep I should do a ‘Those who should be extinct’ list one of these days.
I can’t write about the rest of Britain’s monarchy as my emails then may be tapped! Shit, in saying that my emails may now be being tapped.
Thanks as always for your interest and time my friend, it is much appreciated!!
Hugh
LikeLike